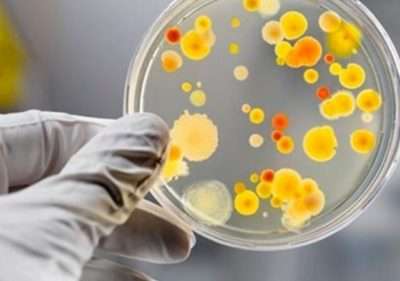

Сальмонели – це бактерії, які викликають кишкові інфекції: сальмонельоз і черевний тиф. Розповідаємо, як запобігти цим інфекціям і що робити в разі зараження.
Сальмонели живуть у кишковому тракті тварин і людей, тому поширюються разом із фекаліями через ґрунт, водойми, харчі чи будь-які інші забруднені поверхні.
Симптоми сальмонельозу такі: діарея, біль у животі та гарячка, та бувають випадки і безсимптомного перебігу цієї інфекції. Перші симптоми з’являються протягом трьох діб після зараження і тривають до тижня. Втім, можливий і тяжкий перебіг сальмонельозу, внаслідок якого розвивається так званий реактивний артрит, що триває місяцями, а деякі люди страждають на діарею кілька місяців після видужання.
Якщо у вас чи дитини симптоми кишкової інфекції – повідомте про це своєму лікарю, телефоном, зокрема. Лікар скерує ваші дії: це може бути приймання антибіотиків, здача аналізів чи просто запобігання зневодненню, адже легкі форми сальмонельозу минають і без лікування. Якщо зараження сталося в межах дитячого табору, школи, садочка, військової частини чи лікарні, про це слід повідомити лікарю закладу, щоб швидко зупинити поширення інфекції.
Люди можуть заразитися сальмонелами через такі джерела:
- харчі тваринного походження: яловичину, курятину, непастеризоване молоко чи яйця;
- брудні чи помиті зараженою водою овочі та фрукти;
- харчі, яких торкалася брудними руками заражена людина;
- контакт зі свійськими й дикими тваринами, фекаліями тварин чи землею, якою тварини гуляють;
- контакт із забрудненими поверхнями, за яким йде торкання обличчя чи харчів;
- брак гігієни після туалету чи зміни підгузків;
- вживання непастеризованого молока чи забрудненої води.
Виглядає так, що заразитися сальмонелами дуже просто і загрози практично всюди, особливо в дитячих їдальнях, чи за умов затоплення і браку води. Для того щоб уберегтися від інфекції, потрібно дотримуватися низки правил.